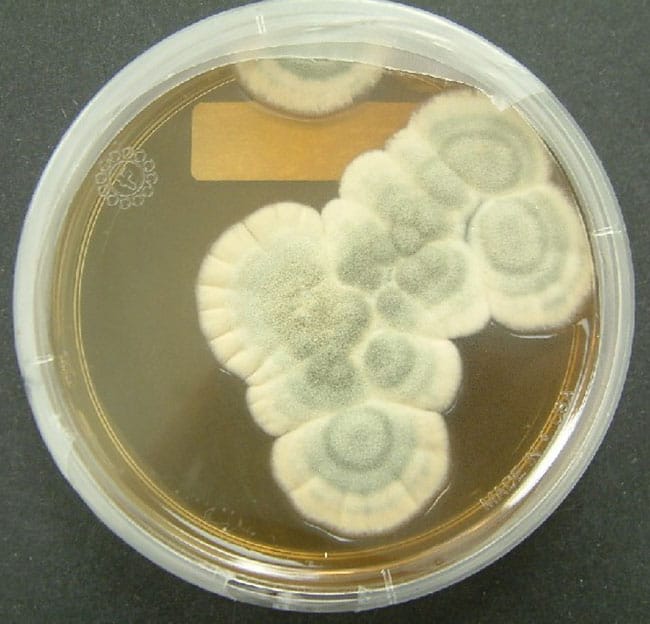
انفلونزا, جراثيم, برد, فصل الشتاء

الجراثيم في علم الأحياء، هي مسببات الأمراض، وعادة ما يستخدم مصطلح «الجرثومة» لوصف الكائنات الحية الدقيقة المعدية؛ مثل البكتيريا والفيروسات والفطريات وغيرها من الميكروبات التي تسبب العدوى. تموت بعض الجراثيم فور خروجها من الجسم، بينما هناك جراثيم أخرى تعيش لساعات أو أيام وربما سنوات.
فيروسات البرد: البقاء في اليد يدوم ساعات
نزلات البرد هي أكثر الأمراض شيوعاً، ويعاني الأشخاص في الولايات المتحدة الأميركية بحوالي مليار نزلة برد كل عام، والمسبب الرئيسي لنزلات البرد هي الفيروسات الأنفية، والتي تساهم أيضاً في حدوث حوالي نصف حالات الإصابة بالربو. ومن المعروف أن أكثر من 200 فيروس مختلف يسبب أعراض نزلات البرد، بما يقدر بنحو 30 - 35% من جميع نزلات البرد البالغة ناجمة عن فيروسات الأنف.
بشكلٍ عام يمكن تبقى أن الفيروسات لفترة أطول على الأسطح غير المسامية؛ أي الأسطح المقاومة للماء مثل الفولاذ المقاوم للصدأ والبلاستيك، وتقل المدة في الأسطح المسامية مثل الأقمشة والأنسجة. وعلى الرغم من أن فيروسات نزلات البرد تعيش على الأسطح لعدة أيام، إلا أن قدرتها على التسبب في العدوى تقل سريعاً، وغالباً ما تستمر لفترة أطول من 24 ساعة، أما الفيروسات الأنفية بشكلٍ خاص فتعيش خارج جسم الإنسان لعدة ساعات.
حققت دراسة حديثة[1] في انتقال فيروسات الأنف عن طريق الاتصال من شخصٍ إلى آخر عبر الاتصال باليد؛ وهو الطريق الرئيسي لنقل العدوى التنفسية البشرية الأكثر انتشاراً في جميع أنحاء العالم. خلصت الدراسة إلى أن فيروسات الأنف يمكن أن تعيش على الأيدي لعدة ساعات.
الأنفلونزا: قوية داخل الجسم فقط
يختلط على بعض الناس التفرقة بين نزلات البرد والأنفلونزا، نظراً لأن أعراضهما متشابهة. الاختلاف هو أن الأنفلونزا تكون أكثر حدة، كما أن الفيروسات الناقلة لها مختلفة. فنزلة البرد تصيب بشكلٍ رئيسي الأنف والحلق، ويظهر المرض تدريجياً، ويمكن لمصاب بنزلة البرد أن يذهب إلى العمل، أما الأنفلونزا فتصيب أكثر من الأنف والحلق، وتظهر في غضون ساعات قليلة، ويشعر المريض بالإرهاق وعدم القدرة على الاستمرار على نحو طبيعي.
الأنفلونزا فيروس قوي داخل الجسم، لكن الأمر يختلف خارجه، وفي دراسة أجريت عام 1982، وجد العلماء أن الأنفلونزا تظل معدية لمدة تصل إلى 48 ساعة على الأسطح الصلبة، بينما في دراسة نشرت عام 2008 وجدت أن الفيروسات ظلت معدية لمدة تصل إلى 3 أيام على الأوراق النقدية. وفي دراسة أخرى عام 2011، أخذ فريق من العلماء سلالتين من فيروسات الأنفلونزا، وحللوا قدرتهم على العدوى من خلال مجموعة متنوعة من الأسطح المنزلية. بعد 9 ساعات فقط؛ لم تعد الفيروسات لديها القدرة على العدوى.
وجدت دراسة أجريت في عام 2006 أن أنفلونزا الطيور كانت قوية بشكلٍ خاص، واستمرت لمدة 6 أيام على بعض الأسطح، لكن إجمالاً تفقد أغلب فيروسات الأنفلونزا قدرتها على العدوى خارج الجسم خلال 24 ساعة تقريباً، وتتضاءل قدرتها بشكلٍ أسرع على المواد المسامية مثل الأنسجة.
الفيروسات: تدوم أسابيع أو تموت لحظياً
فيروس «نوروفيروس»، هو فيروس شديد العدوى، ويشار إليه أحياناً بأنفلونزا المعدة. ينقل الفيروس عن طريق الاتصال المباشر مع شخص مصاب، أو من خلال لمس سطح ملوث بالفيروس. تشمل أعراضه الغثيان وآلام في المعدة والقيء والإسهال، ويظهر عادة خلال يوم أو يومين، ثم يستمر من يومين إلى 3 أيام. تختلف دورة حياة هذا الفيروس؛ على سبيل المثال يمكنه أن يعيش لأسابيع على الأسطح الصلبة سواء طاولة أو زر المصعد، أو حتى على مقبض الباب، ولا يموت باستخدام المطهرات.
رغم أن فيروس «هربس» يسبب مرض شديد العدوى؛ إلا أنه يموت بمجرد مغادرته لجسم الإنسان المضيف له. لذا ينتقل الفيروس عن طريق الاتصال الجنسي، والتقبيل، وفي بعض الأحيان ينتقل من خلال ملامسة الفيروس نفسه لجروح أو خدوش الشخص المصاب.
البكتيريا: تتعايش وتنمو وتهاجم الإنسان
البكتيريا هي كائنات حية دقيقة، ولها أنواع كثيرة وتتأخذ أشكالاً عديدة. هناك نوعان من البكتيريا التي تسبب العديد من الإصابات الشائعة لدى الأطفال وكبار السن، مثل التهاب الحلق والرئة والتهابات الأذن الوسطى. وجد باحثون من جامعة «بافالو» في نيويورك؛ أن بكتيريا المكورة الرئوية، وبكتيريا المكورة العقدية المقيحة تعيش على العديد من الأسطح لفترة أطول مما كان يعتقد سابقاً. كانت الدراسات السابقة تشير إلى أن البكتيريا تموت بسرعة بمجرد أن تغادر جسم الإنسان.
توصل الباحثون في جامعة بافالو إلى أن بكتيريا المكورة الرئوية وبكتيريا المكورة العقدية المقيحة؛ يمكنها البقاء حية لعدة ساعات على الأسطح. كما تبين أن كلا النوعين يمكنهم التعايش وتكوين أغشية حيوية رقيقة، ويمكن لهذا العوامل الممرضة أن تعيش لفترات طويلة خارج مضيف بشري. كما وجد الباحثون أن الأشياء شائعة الاستخدام، والملوثة ببكتيريا الأغشية الحيوية، يمكن أن تعمل كخزانات للبكتيريا لساعات أو أسابيع أو أشهر، مما ينشر العدوى المحتملة للأفراد الذين يتلامسون معها.
الفطريات: تتكاثر وتعيش عقوداً
لا تتوقف الجراثيم المسببة للأمراض عند الفيروسات والبكتيريا، هناك الفطريات والطفيليات. تعيش الفطريات في الهواء الطلق والتربة، وعلى النباتات، وكذلك على العديد من الأسطح الداخلية، وعلى الجلد البشري. وعلى الرغم من أن هناك الملايين من الأنواع المختلفة من الفطريات على الأرض، فمن المعروف أن 300 نوعاً فقط هم المسببين للأمراض، مثل الالتهابات الفطرية الجلدية الخفيفة (الطفح الجلدي).
الفطريات مملكة خاصة بها، لا تصنف ضمن النباتات ولا الحيوانات، وغالباً ما تنمو في التربة وتحلل المواد النباتية، وتتكاثر عن طريق نشر جراثيم مجهرية. لذا يمكنها أن تعيش عقوداً وربما قرون، وغالباً ما توجد هذه الجراثيم في الهواء والتربة، ويمكن استنشاقها أو يمكنها التسبب بالمرض عبر ملامسة الجلد. لذا عادة ما تبدأ الالتهابات الفطرية في الرئتين أو الجلد، لكن الجيد أن أغلب الفطريات لا تسبب العدوى بخلاف مجموعة قليلة تسبب ذلك في الأشخاص الذين لديهم ضعف في الجهاز المناعي، أو مواد غريبة في الجسم؛ بما في ذلك الأجهزة الطبية. وباستثناء بعض الالتهابات الجلدية السطحية، نادراً ما تنتقل العدوى الفطرية من شخصٍ لآخر.
ختاماً، كانت هذه رحلة موجزة إلى عالم الجراثيم بأنواعها المختلفة، فأي منها أثار اهتمامك بشكلٍ كبير؟
المصادر:
[1]: Survival of rhinoviruses on human fingers




